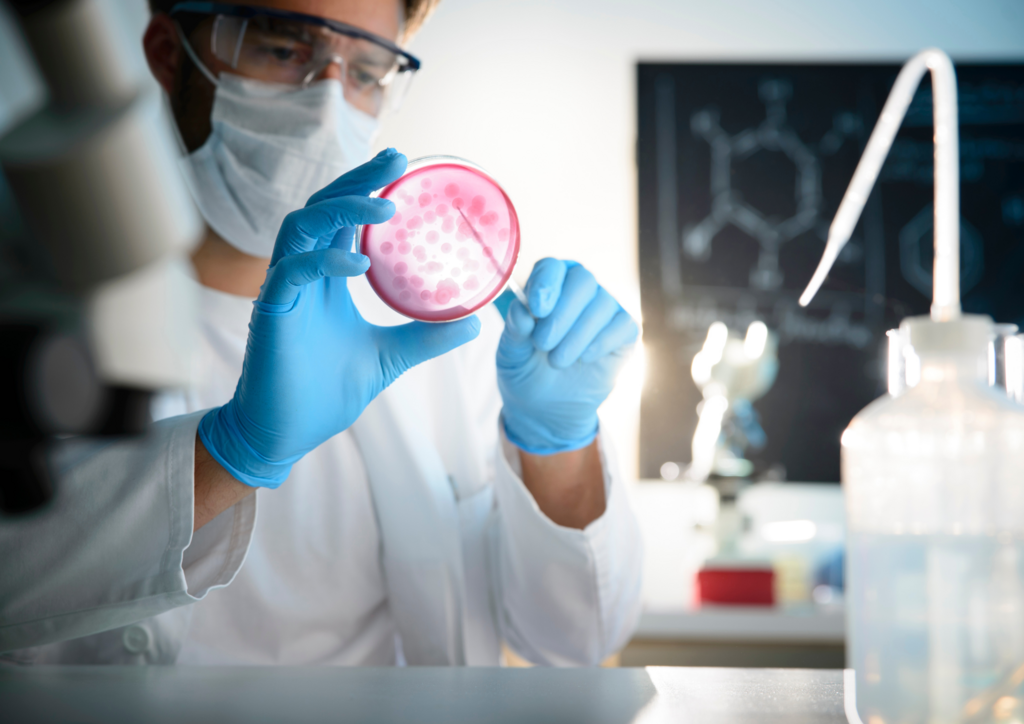

Otsing
Koolituskalender

Toitumise baaskoolitus I
Toimumisaeg: september 2026 – juuni 2027
Maht: 553 akadeemilist tundi
Koolitajad: Ivi Vaher, Katrin Tint, Külli Holsting, Katrin Laikoja, Mari Reinik, Kristel Ehala-Aleksejev, Ester Jaansoo, Kristi Vahur, Helen Udras, Inga Ploomipuu, Sirje Sammul, Janika Pael, Mai Treial, Maarja Randväli, Aive Antson, Hanna-Liis Lepp, Diana Liivola
Hind: 1985€

Täiskasvanud patsiendi terviklik terviseseisundi esmane hindamine, kliiniline otsustusprotsess ja dokumenteerimine: praktiline koolitus pereõdedele
Toimumisaeg: 19. veebruar- 6. aprill 2026
Maht: 52 akadeemilist tundi
Koolitajad: Sirje Sammul, Pille Tammpere, Janika Pael, Haide Laurson
Hind: 350€

Basic body awareness therapy
Toimumisaeg: 13. jaanuar 2026 -23. aprill 2026
Maht: 156 akadeemilist tundi
Koolitajad: Marin Rändur
Hind: 450€

Õed tagasi tervishoidu
Toimumisaeg: 22. jaanuar 2026 – 16. juuni 2026
Maht: 780 akadeemilist tundi
Koolitajad: Tartu Tervishoiu Kõrgkooli õppejõud
Hind: Sihtrühmale suunatud tasuta koolitus!

Immuniseerimisalane baaskoolitus
Toimumisaeg: 12. veebruar- 13. veebruar 2026
Maht: 32 akadeemilist tundi
Koolitaja: Sirje Sammul
Hind: 150€

Diabeedihaige hooldus
Toimumisaeg: 25. veebruar – 27. veebruar 2026
Maht: 24 akadeemilist tundi
Koolitaja: Piret Simm-Pärle
Hind: Sihtrühmale suunatud tasuta koolitus!

Histoloogia töötuba
Toimumisaeg: 26. veebruar 2026
Maht: 2 akadeemilist tundi
Koolitaja: Deivi Roomets
Hind: Tasuta

Kliinilise keemia töötuba „Lipiidide ainevahetuse uurimine kliinilises praktikas“
Toimumisaeg: 26. veebruar 2026
Maht: 2 akadeemilist tundi
Koolitajad: Kaido Liiv, Aivar Orav
Hind: Tasuta

Molekulaardiagnostika töötuba „Streptococcus mutans’i määramine hambakaapest PCR meetodil“
Toimumisaeg: 26. veebruar 2026
Maht: 3 akadeemilist tundi
Koolitaja: Sirli Anniko
Hind: Tasuta

Hematoloogia töötuba „Hemogramm ja vereäiged“
Toimumisaeg: 26. veebruar 2026
Maht: 2 akadeemilist tundi
Koolitajad: Ingrid Orav, Anneli Raave-Sepp
Hind: Tasuta
Mikrobioloogia töötuba „Uriini mikrobioloogiline uuring“
Toimumisaeg: 26. veebruar 2026
Maht: 2 akadeemilist tundi
Koolitaja: Marika Külm
Hind: Tasuta

Töötuba „Veregruppide määramine laboris“
Toimumisaeg: 26. veebruar 2026
Maht: 2 akadeemilist tundi
Koolitaja: Anette Reiu
Hind: Tasuta

Toitumine, liikumine ja tervis (veebikoolitus)
Toimumisaeg: 26. veebruar – 5. märts 2026
Maht: 5 akadeemilist tundi
Koolitaja: Triin Nõmmistu
Hind: 65€

Sensoorsed lood
Toimumisaeg: 5. märts – 19. mai 2026
Maht: 26 akadeemilist tundi
Koolitaja: Riin Tamm
Hind: 85€

Vene keel tervishoiutöötajale
Toimumisaeg: 9.-16. märts 2026
Maht: 20 akadeemilist tundi
Koolitaja: Olga Jagintseva
Hind: 120€

Tööalaste tunnete ja emotsioonidega toimetulek peale tööd
Toimumisaeg: 10. märts 2026
Maht: 8 akadeemilist tundi
Koolitaja: Nele Kalf
Hind: 80€

Näo fitnessmassaaž
Toimumisaeg: 11. – 19. märts 2026
Maht: 32 akadeemilist tundi
Koolitaja: Mai-Liis Pille
Hind: 265€

Ergonoomika patsiendi siirdumistel
Toimumisaeg: 12. märts 2026
Maht: 9 akadeemilist tundi
Koolitaja: Triin Nõmmistu
Hind: 100€

Lapse esmaabi koolitus
Toimumisaeg: 12. märts 2026
Maht: 8 akadeemilist tundi
Koolitaja: Taimi Taimalu
Hind: 65€

Töötervishoiu ja -ohutuse alane täiendkoolitus
Toimumisaeg: 24. märts 2026
Maht: 8 akadeemilist tundi
Koolitaja: Silja Soon
Hind: 85€

Raske ja sügava dementsusega inimese elukvaliteedi toetamine
Toimumisaeg: 26. märts 2026
Maht: 8 akadeemilist tundi
Koolitaja: Janika Pael
Hind: 90€

Ergonoomika kontoritöötajale
Toimumisaeg: 9. aprill 2026
Maht: 2 akadeemilist tundi
Koolitaja: Triin Nõmmistu
Hind: 55€
Toimumiskoht: Tallinn, Ülemiste City

Sünnitusjärgsest taastumisest ämmaemandatele
Toimumisaeg: 9. aprill 2026
Maht: 5 akadeemilist tundi
Koolitaja: Triin Nõmmistu
Hind: 75€
Toimumiskoht: Tallinn, Ülemiste City

Laboritöö alused
Toimumisaeg: 13. aprill – 17. aprill 2026
Maht: 55 akadeemilist tundi
Koolitajad: Kaido Liiv, Mai Treial, Aivar Orav, Eerik Jõgi, Lisete Õispuu, Lia Oja
Hind: Sihtrühmale suunatud tasuta koolitus!

Kriisid, nende anatoomia, mõistmine ja toimetulek
Toimumisaeg: 16. aprill 2026
Maht: 8 akadeemilist tundi
Koolitaja: Nele Kalf
Hind: 80€

Mikrobioloogia alused
Toimumisaeg: 21. aprill – 29. aprill 2026
Maht: 50 akadeemilist tundi
Koolitajad: Marika Külm, Anette Reiu
Hind: Sihtrühmale suunatud tasuta koolitus!

Esmaabi väljaõppe koolitus
Toimumisaeg: 21.-22. aprill 2026
Maht: 16 akadeemilist tundi
Koolitaja: Svetlana Kalmaznina
Hind: 90€

Perifeerse veeni punktsioon ja kanüleerimine
Toimumisaeg: 27. aprill 2026
Maht: 7 akadeemilist tundi
Koolitaja: Anneli Pärn
Hind: 80€

Diabeedihaige hooldus
Toimumisaeg: 27. aprill – 29. aprill 2026
Maht: 24 akadeemilist tundi
Koolitaja: Piret Simm-Pärle
Hind: Sihtrühmale suunatud tasuta koolitus!

Sünnitusjärgsest taastumisest emadele (veebikoolitus)
Toimumisaeg: 30. aprill 2026
Maht: 4 akadeemilist tundi
Koolitaja: Triin Nõmmistu
Hind: 65 €

Hooldustoimingute alane täienduskoolitus
Toimumisaeg: 11. mai – 14. mai 2026
Maht: 30 akadeemilist tundi
Koolitajad: Triin Nõmmistu, Taimi Taimalu, Ljudmila Schmidt
Hind: Sihtrühmale suunatud tasuta koolitus!

Suitsiidiennetusest õdedele
Toimumisaeg: 12. mai 2026
Maht: 8 akadeemilist tundi
Koolitaja: Aile Sumberg-Almers
Hind: 110 €

Immuniseerimisalane jätkukoolitus
Toimumisaeg: 12. mai 2026
Maht: 11 akadeemilist tundi
Koolitaja: Sirje Sammul
Hind: 105 €

Preanalüütika (veebikoolitus)
Toimumisaeg: 13. mai 2026
Maht: 13 akadeemilist tundi
Koolitaja: Aivar Orav
Hind: 85 €

Surma ja leina mõistmine, toimetulek
Toimumisaeg: 21. mai 2026
Maht: 6 akadeemilist tundi
Koolitaja: Nele Kalf
Hind: 85 €

Lähedase hooldamine kodus
Toimumisaeg: 25. mai – 8. juuni 2026
Maht: 46 akadeemilist tundi
Koolitajad: Triinu Kurvits, Kristiina-Maria Lorenz, Helina Pedak, Triin Nõmmistu, Janika Pael, Katrin Tint, Eve-Merike Sooväli, Ivi Vaher, Anne Vahtramäe, Merle Varik
Hind: Sihtrühmale suunatud tasuta koolitus!

Gait Analysis and Orthotic Management in Neurological Rehabilitation
Toimumisaeg: 26. mai 2026
Maht: 35 akadeemilist tundi
Koolitaja: Kostiantyn L. Kalinkin
Hind: 175€

Esmaabi täienduskoolitus
Toimumisaeg: 26. mai 2026
Maht: 8 akadeemilist tundi
Koolitaja: Svetlana Kalmaznina
Hind: 70 €

Sissekasvanud küüs ja selle lahendamine klambritega
Toimumisaeg: 28. mai 2026
Maht: 9 akadeemilist tundi
Koolitaja: Erika Gering
Hind: 165 €

Elulõpuravist hooldustöötajatele
Toimumisaeg: 4. juuni 2026
Maht: 6 akadeemilist tundi
Koolitaja: Svetlana Gromova
Hind: 90 €

